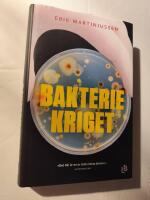
Bakteriekriget

-

Etnologiskt fältarbete
Häftad bok. Studentlitteratur AB. 2 uppl. 2011. 296 sidor.
Mycket gott skick. Anteckningar och markeringar till sidan 32
Inrikes enhetsfrakt Sverige: 62 SEK- ISBN
- 9789144058528
- Titel
- Etnologiskt fältarbete
- Författare
- Kaijser, Lars
- Förlag
- Studentlitteratur AB
- Utgivningsår
- 2011
- Omfång
- 296 sidor
- Bandtyp
- Häftad
- Mått
- 122 x 200 mm Ryggbredd 15 mm
- Vikt
- 310 g
- Språk
- Svenska
- Baksidestext
- Fältarbete är en grundläggande och ofta använd metod inom etnologisk forskning. Den som ska utföra en undersökning ställs inför flera frågor. Hur förbereder jag fältarbetet? Vilka metoder är lämpliga? Vilken är min egen roll ute i fält? Hur gör man intervjuer och observationer? Kan Internet och arkivmaterial inkluderas i fältarbete? I den här boken ges en utförlig beskrivning av det etnologiska fältarbetets grunder. Inledningsvis redogör författarna för generella utgångspunkter och ramar vid ett fältarbete. Därefter följer en rad kapitel som enskilt fokuserar olika tekniker och metoder såsom intervjuer, observation samt fotografi och film. I denna grundligt omarbetade och utökade utgåva har det tillkommit tre nyskrivna kapitel; ett om Internet, ett om arkiv och ett om analyser baserade på fältmaterial.Etnologiskt fältarbete är en både tankeväckande och handfast lärobok som vänder sig till studenter på grundnivå i etnologi och angränsande ämnen.
Studentlitteratur AB 2 9789144058528 -

Democratization
Häftad bok. Polity Press. 1997. 550 sidor.
Mycket gott skick. En reva på 2cm på bakre pärm
Inrikes enhetsfrakt Sverige: 62 SEK- ISBN
- 9780745618159
- Titel
- Democratization
- Författare
- Potter, David S.
- Förlag
- Polity Press
- Utgivningsår
- 1997
- Bandtyp
- Språk
- English
- Baksidestext
Ytterligare författare: Potter, David S.
Polity Press 9780745618159 -

History: a very short introduction
Häftad bok. Oxford University Press. 2000. 160 sidor.
Mycket gott skick.
Inrikes enhetsfrakt Sverige: 62 SEK- ISBN
- 9780192853523
- Titel
- History [elektronisk resurs] : a very short introduction
- Författare
- Arnold, John
- Förlag
- Oxford ; New York : Oxford University Press
- Utgivningsår
- 2000
- Språk
- English
- Baksidestext
- Includes bibliographical references (p. 127-130) and index.
Description based on print version record.
Imported from: acorn.library.vanderbilt.edu:2200/unicorn (Do not remove)
Oxford University Press 9780192853523 -
 Inrikes enhetsfrakt Sverige: 62 SEK
Inrikes enhetsfrakt Sverige: 62 SEK- ISBN
- 9789147100002
- Titel
- Boken om pedagogerna
- Författare
- Forssell, Anna
- Förlag
- Liber
- Utgivningsår
- 2011
- Omfång
- 480 sidor
- Bandtyp
- Häftad
- Vikt
- 556 g
- Språk
- Svenska
- Baksidestext
- Boken om pedagogerna är en antologi för dig som vill förstå varför den svenska skolan ser ut som den gör. I denna nya bearbetade upplaga har det tillkommit kapitel om digitalisering, segregation och frågan om inkludering.
Läs mer
Trots att vi lever i en föränderlig tid är de stora pedagogiska frågorna desamma nu som då: vad är pedagogik, vad är viktig kunskap, hur går lärande till, vilka medborgerliga dygder ska skolan förmedla, vilken är skolans roll i samhället, och hur skall skolan styras och organiseras så att alla barn och unga ges likvärdiga möjligheter att utvecklas maximalt?
Genom att tränga bakom retoriken och de pedagogiska trenderna tecknar bokens författare hur man i olika tider svarat på de eviga frågeställningarna om kunskap, bildning och rätten till personligt växande, och hur dessa svar formar och har format svensk skola.
Om författarna
Anna Forssell (red) är undervisningsråd på Skolverket och fil dr. vid Stockholms universitet. Författarna till boken är de mest namnkunniga inom sina respektive områden i Sverige.
Liber 6 9789147100002 -

Duden : Die schriftliche Arbeit - für schule,...
Häftad bok. Bibliographisches Institut. 3 uppl. 2019. 95 sidor.
Nära nyskick.
Inrikes enhetsfrakt Sverige: 62 SEK- ISBN
- 9783411745739
- Titel
- Duden : Die schriftliche Arbeit - für schule, hochschule und universität
- Författare
- Niederhauser, Jürg
- Förlag
- Bibliographisches Institut
- Utgivningsår
- 2019
- Omfång
- 95 sidor
- Bandtyp
- Häftad
Bibliographisches Institut 3 9783411745739 -

Lärande i praktiken - Ett sociokulturellt per...
Häftad bok. Studentlitteratur AB. 3 uppl. 2014. 280 sidor.
Mycket gott skick. Är ett fåtal markeringar i boken med blyerts
Inrikes enhetsfrakt Sverige: 62 SEK- ISBN
- 9789144101736
- Titel
- Lärande i praktiken - Ett sociokulturellt perspektiv
- Författare
- Säljö, Roger
- Förlag
- Studentlitteratur AB
- Utgivningsår
- 2014
- Omfång
- 280 sidor
- Bandtyp
- Häftad
- Mått
- 155 x 228 mm Ryggbredd 15 mm
- Vikt
- 420 g
- Språk
- Svenska
- Baksidestext
- Att omvärlden och den kultur en människa lever i har stor betydelse för hennes sätt att lära och utvecklas är de flesta lärare och pedagoger medvetna om. Men hur ser egentligen samspelet mellan lärande och omvärld ut? Och vilken inverkan har traditioner, förväntningar och den kommunikativa miljön på lärandet? Det är frågor av detta slag som Roger Säljö tar upp i Lärande i praktiken – ett sociokulturellt perspektiv, den första boken på svenska som tar upp detta fascinerande ämne.
Genom att betrakta lärande ur ett sociokulturellt perspektiv och börja långt tillbaka i mänsklighetens historia då kunskaper och tekniker började utvecklas på allvar, växer så småningom fram en bild av människans möjligheter och begränsningar som är både tankeväckande och samtidigt manar till handling i enlighet med de observationer som presenteras. Vad var goda läs- och skrivfärdigheter för femtio år sedan och vad krävs idag? Hur lär man i samhällen som inte använder skrift eller andra tekniker för att kommunicera? Hur formas vi av språk, teknik och kultur? Vår hjärna har inte blivit större eller mer väloljad under de senaste årtusendena, men det har inte hindrat vår förmåga att utveckla kunskaper och tekniker på ett häpnadsväckande sätt.
Lösningen på denna gåta är att vi utvecklar och bevarar en del kunskaper och insikter i huvudet och kroppen, och andra delar förlägger vi i alltmer sofistikerade redskap utanför oss själva. Som en följd av denna rastlösa utveckling ändrar sig hela tiden våra sätt att lära och tänka.
Denna titel har tidigare givits ut av Norstedts men ingår numera i Studentlitteraturs sortiment. Denna tredje upplaga innehåller dock inga förändringar av innehållet jämfört med den andra upplagan.
Studentlitteratur AB 3 9789144101736 -

Kultur : den flexibla gemenskapen
Häftad bok. Studentlitteratur. 1 uppl. 2010. 205 sidor.
Nära nyskick.
Inrikes enhetsfrakt Sverige: 62 SEK- ISBN
- 9789144067995
- Titel
- Kultur : den flexibla gemenskapen
- Författare
- Hastrup, Kirsten
- Förlag
- Studentlitteratur
- Utgivningsår
- 2010
- Omfång
- 205 sidor
- Bandtyp
- Häftad
- Mått
- 155 x 223 mm Ryggbredd 10 mm
- Vikt
- 310 g
- Språk
- Svenska
- Baksidestext
- Kulturbegreppet tränger sig på. Det är inte längre förbehållet ett fåtal att uttala sig om kultur när globalisering, migration och högteknologisk kommunikation har konfronterat de flesta med bilder av och kunskap om helt andra sätt att leva. Kultur har blivit ett av de globala begrepp, som används för att förstå världens mångfald. Kultur knyter förbindelser och skapar gränser – berikar och begränsar människors utforskning av tillvaron. Kultur kan både brukas och missbrukas. I den här boken ses kulturen ur en rad olika perspektiv, som nyanserar och kompletterar varandra och som tillsammans visar kulturens komplexitet. Oavsett synsätt eller måttstock pekar kulturen i en riktning mot gemenskap. Det enskilda är alltid en del av en större helhet, som både bekräftas och utmanas genom individuell handling. Gemenskapen är flexibel; den ändrar sig i takt med att människor gör nya erfarenheter. I det ljuset är kulturen en öppning mot oanade möjligheter snarare än ett tankens fängelse .Boken är främst avsedd för studenter i kulturvetenskapliga ämnen vid universitet och högskolor. Den inleds med ett svenskt förord av Orvar Löfgren. Översättning: Sven-Erik Torhell
Studentlitteratur 1 9789144067995 -

The ethnographer's eye : ways of seeing in an...
Häftad bok. Cambridge Univ. Press. 5 uppl. 2007. 222 sidor.
Mycket gott skick.
Inrikes enhetsfrakt Sverige: 62 SEK- ISBN
- 9780521774758
- Titel
- The ethnographer's eye : ways of seeing in anthropology
- Författare
- Grimshaw, Anna
- Förlag
- New York : Cambridge Univ. Press
- Utgivningsår
- 2001
- Språk
- English
Cambridge Univ. Press 5 9780521774758 -

InterNacionalistas : identifikation och främl...
Häftad bok. H:ström Text & Kultur. 1 uppl. 2007. 308 sidor.
Mycket gott skick. ett hundöra på sidan 133
Inrikes enhetsfrakt Sverige: 62 SEK- ISBN
- 9789173270342
- Titel
- InterNacionalistas : identifikation och främlingskap i svenska solidaritetsarbetares berättelser från Nicaragua
- Författare
- Berg, Linda
- Förlag
- H:ström Text & Kultur
- Utgivningsår
- 2007
- Omfång
- 308 sidor
- Bandtyp
- Häftad
- Mått
- 147 x 211 mm Ryggbredd 20 mm
- Vikt
- 430 g
- Språk
- Svenska
- Baksidestext
- "Internacionalistas" kallades vanligtvis västerlänningar som reste till landet i samband med den sandinistiska revolutionen 1979. Termen finns kvar och används ibland på svenska solidaritetsarbetare som ett sätt att markera att deras närvaro handlar om en gemensam strävan, en kamp för ideal bortom nationella gränser. Men hur hanterar man att vara en privilegierad svensk när man vill finnas till som en jämlike? Hur berättar man för andra om vad man har gjort och hur berättar man om Nicaragua? Revolution, korruption, naturkatastrofer?
Boken uppmärksammar vad skildringar av Nicaragua till Sverige gör med människor och miljöer och visar på svårigheterna att upprätta globala gemenskaper i en postkolonial samtid. Med ett postkolonialt perspektiv fokuseras särskilt hur formulerade identiteter speglar nationaliserande, rasifierande och könande föreställningar, samt hur dessa hanteras inom ramen för en rörelse med ambition att verka för global rättvisa.
H:ström Text & Kultur 1 9789173270342 -
Bakteriekriget
Inbunden bok. Louise Bäckelin Förlag. 2020. 412 sidor.
Nyskick. Skyddsomslag i nyskick. Recensions ex stämplat på övre snitt
Inrikes enhetsfrakt Sverige: 62 SEK- ISBN
- 9789177992226
- Titel
- Bakteriekriget
- Författare
- Martiniussen, Erik
- Förlag
- Louise Bäckelin Förlag
- Utgivningsår
- 2020
- Omfång
- 412 sidor
- Bandtyp
- Inbunden
- Mått
- 145 x 218 mm Ryggbredd 33 mm
- Vikt
- 582 g
- Språk
- Svenska
- Baksidestext
- Vi står inför den största hälsokatastrofen världen har skådat. Kan vi bekämpa den?Varje år dör 700 000 personer av antibiotikaresistenta bakterier världen över. I USA tar resistenta bakterier livet av tre gånger så många människor som HIV och AIDS. Världshälsoorganisationen varnar för att den medicinska vetenskapen kommer att återgå till vad den var för 100 år sedan utan antibiotika. Vi kommer att stå försvarslösa mot vanliga infektioner och enkla ingrepp blir omöjliga att utföra. Innan år 2050 kommer 10 miljoner människors liv att vara i fara varje år. Den största hälsokatastrofen världen har skådat står för vår tröskel, ändå är det knappt någon som talar om den. Bakteriekriget avslöjar det cheferna för läkemedelsindustrin, sjukhusen och köttindustrin inte vill att du ska veta. Det är chockerande uppgifter om hur jakten på vinst har drivit läkemedelsindustrin till att distribuera antibiotika som om det vore vitaminer, och om hur köttindustrin systematiskt undanhållit information om en omfattande användning av antibiotika inom lantbruket. Djur och bakterier har i hundratusentals år levt i en balans som den obegränsade konsumtionen av antibiotika nu hotar att sätta ur spel. Finns det något hopp kvar? Ett gammalt botemedel, bevarat av läkare och sjuksköterskor i Georgien, är på väg att återupptäckas och det kan komma att ändra den medicinska historien igen. ERIK MARTINIUSSEN är en norsk journalist och författare. Han har tidigare skrivit boken Drivhuseffekten."I boken presenteras spännande, skrämmande och även hoppingivande fakta i reportageform på ett lättläst sätt. Läsaren upplever sig betydligt kunnigare och mer rustad för tillvaron efter att ha plöjt de 400 sidorna. Boken rekommenderas en bred läsekrets." BTJ"Bakteriekriget är en högintressant och tankeväckande bok som fängslar från första till sista sidan! Utan tvekan är detta en av årets intressantaste böcker! Martiniussens reportagebok är initierad och väldokumenterad och fungerar som en ögonöppnare! Högsta betyg! 5 av 5." Minaboktips.se
Louise Bäckelin Förlag 9789177992226 -
 Inrikes enhetsfrakt Sverige: 62 SEK
Inrikes enhetsfrakt Sverige: 62 SEK- ISBN
- 9781446282410
- Titel
- Methods of critical discourse studies
- Författare
- Wodak, Ruth - Meyer, Michael
- Förlag
- Los Angeles : SAGE
- Utgivningsår
- 2016
- Språk
- English
SAGE 3 9781446282410 -
 Inrikes enhetsfrakt Sverige: 62 SEK
Inrikes enhetsfrakt Sverige: 62 SEK- ISBN
- 9783484311213
- Titel
- Studienbuch Linguistik
- Författare
- Linke, Angelika - Nussbaumer, Markus - Portmann, Paul R.
- Förlag
- Tübingen : Niemeyer
- Utgivningsår
- 2004
- Språk
- English
Niemeyer 5 9783484311213 -

The new United Nations : international organi...
Häftad bok. Upper Saddle River, N.J. Pearson Education. 2006. 358 (21) sidor.
Gott skick. Lite tummad på övre högra hörnet
Inrikes enhetsfrakt Sverige: 62 SEK- ISBN
- 9780131844889
- Titel
- The new United Nations : international organization in the twenty-first century
- Författare
- Moore, John Allphin - Pubantz, Jerry
- Förlag
- Upper Saddle River, N.J. Pearson Education
- Utgivningsår
- 2006
- Språk
- English
- Baksidestext
- Includes bibliographical references and index
Introduction : ways of thinking about the United Nations and international organizations -- The many places of the United Nations -- Origins and history of the United Nations -- The evolving UN Charter -- Evolving institutions -- Maintenance of international peace and security -- Peacekeeping and nation building -- Making global public policy : promoting civil society, human rights, and women's empowerment -- Economic development, the environment, and health policy
Upper Saddle River, N.J. Pearson Education 9780131844889 -

Fransk fonetik
Häftad bok. Natur & Kultur. 3 uppl. 1993. 116 sidor.
Mycket gott skick. Prislapp kvar på bakre pärm
Inrikes enhetsfrakt Sverige: 62 SEK- ISBN
- 9789127630017
- Titel
- Hammarström/Fransk fonetik
- Författare
- Hammarström, Göran
- Förlag
- Natur & Kultur
- Utgivningsår
- 1993
- Omfång
- 116 sidor
- Bandtyp
- Häftad
- Vikt
- 158 g
- Språk
- Svenska
Natur & Kultur 3 9789127630017 -

Personbevis : passets födelse i medeltidens E...
Häftad bok. Glänta Produktion. 2010. 278 sidor.
Nära nyskick. Danskt band
Inrikes enhetsfrakt Sverige: 62 SEK- ISBN
- 9789186133078
- Titel
- Personbevis : passets födelse i medeltidens Europa
- Författare
- Groebner, Valentin
- Förlag
- Glänta Produktion
- Utgivningsår
- 2010
- Omfång
- 278 sidor
- Bandtyp
- Häftad
- Mått
- 135 x 210 mm Ryggbredd 10 mm
- Vikt
- 410 g
- Språk
- Svenska
- Baksidestext
- Vem är du? Och hur kan du bevisa det? Efter den 11 september har kontrollen av resenärer inom och mellan olika länder trappats upp. Valentin Groebners Personbevis handlar om identifieringens förhistoria och historia, från medeltiden till idag. Groebner undersöker samspelet mellan pappren och deras bärare, mellan det äkta och det falska, mellan kontroll och kryphål. Han visar att de identitetshandlingar som vi bär på oss döljer en ansenlig mängd medeltid. Och att historien om dem redan från början är en politisk historia. Efterord av Maria Johansen, idéhistoriker verksam vid Swedish Collegium for Advanced Study i Uppsala. Valentin Groebner är historiker vid universitetet i Luzern, Schweiz, och författare till flera uppmärksammade studier om medeltidens och renässansens historia.
Glänta Produktion 9789186133078 -

Empirisches Arbeiten in Linguistik und Sprach...
Häftad bok. Narr. 2010. 203 sidor.
Mycket gott skick.
Inrikes enhetsfrakt Sverige: 62 SEK- ISBN
- 9783823365907
- Titel
- Empirisches Arbeiten in Linguistik und Sprachlehrforschung - Anleitung zu quantitativen Studien von der Planungsphase bis zum Forschungsbericht
- Författare
- Brons-Albert, Ruth
- Förlag
- Narr
- Utgivningsår
- 2010
- Omfång
- 203 sidor
Narr 9783823365907 -
 Inrikes enhetsfrakt Sverige: 62 SEK
Inrikes enhetsfrakt Sverige: 62 SEK- ISBN
- 9780198706786
- Titel
- Industrial revolution - a very short introduction
- Författare
- Allen, Robert C
- Utgivningsår
- 2017
- Omfång
- 150 sidor
- Bandtyp
- Språk
- English
9780198706786 -

Islamic arts
Häftad bok. Phaidon. 2008. 447 sidor.
Mycket gott skick. Det finns markeringar med märkpenna, nedre hörn på främre pärm har fått en stöt
Inrikes enhetsfrakt Sverige: 62 SEK- ISBN
- 9780714831763
- Titel
- Islamic arts
- Författare
- Bloom, Jonathan
- Förlag
- Phaidon
- Utgivningsår
- 1997
- Omfång
- 447 sidor
Phaidon 9780714831763 -

Study of language
Pocketbok. Cambridge University Press. 3 uppl. 2007. 273 sidor.
Gott skick. Inga anteckningar
Inrikes enhetsfrakt Sverige: 62 SEK- ISBN
- 9780521543200
- Titel
- Study of language
- Författare
- George Yule
- Förlag
- Cambridge University Press
- Utgivningsår
- 2005
- Omfång
- 284 sidor
- Bandtyp
- Mått
- 174 x 247 mm
- Vikt
- 571 g
- Språk
- Svenska
Cambridge University Press 3 9780521543200 -

En patriotisk drömvärld : musik, nationalism...
Häftad bok. Acta Universitatis Upsaliensis : Uppsala University Library [distributör. 2008. 232 sidor.
Nära nyskick.
Inrikes enhetsfrakt Sverige: 62 SEK- ISBN
- 9789155472849
- Titel
- En patriotisk drömvärld : musik, nationalism och genus under det långa 1800-talet = Patriotic dreamlands : music, nationalism and gender in the long nineteenth century
- Författare
- Enefalk, Hanna
- Förlag
- Uppsala : Acta Universitatis Upsaliensis : Uppsala University Library [distributör
- Utgivningsår
- 2008
- Språk
- Svenska
Acta Universitatis Upsaliensis : Uppsala University Library [distributör 9789155472849 -

Writing academic english
Häftad bok. Gardners Bokimporten. 4 uppl. 2006. 337 sidor.
Mycket gott skick. Spår av prislapp på bakre pärm
Inrikes enhetsfrakt Sverige: 62 SEK- ISBN
- 9780131523593
- Titel
- Writing academic english
- Författare
- Oshima, Alice
- Förlag
- Gardners Bokimporten
- Utgivningsår
- 2005
- Omfång
- 337 sidor
- Bandtyp
- Mått
- 210 x 274 mm Ryggbredd 12 mm
- Vikt
- 630 g
- Språk
- English
Gardners Bokimporten 4 9780131523593 -

The Norton introduction to literature
Häftad bok. New York : W. W. Norton & Co. 10 uppl. 2010. Många sidor.
Mycket gott skick. Ett par fläckar på långa snittet
Inrikes enhetsfrakt Sverige: 62 SEK- ISBN
- 9780393935141
- Titel
- The Norton introduction to literature
- Författare
- Booth, Alison - Mays, Kelly J.
- Förlag
- New York : W. W. Norton & Co
- Utgivningsår
- 2010
- Språk
- English
- Baksidestext
- Includes bibliographical references and index.
Dawson
New York : W. W. Norton & Co 10 9780393935141 -

An introduction to syntax
Häftad bok. Cambridge Univ. Press. 2005.
Mycket gott skick. Blyertsanteckningar
Inrikes enhetsfrakt Sverige: 62 SEK- ISBN
- 9780521635660
- Titel
- An introduction to syntax
- Författare
- Van Valin, Robert D.
- Förlag
- Cambridge : Cambridge Univ. Press
- Utgivningsår
- 2001
- Språk
- English
Cambridge Univ. Press 9780521635660 -

Sociolinguistics - a reader and coursebook
Häftad bok. Palgrave Macmillan. 1997. 520 sidor.
Mycket gott skick. spår av prislapp på bakre pärm
Inrikes enhetsfrakt Sverige: 62 SEK- ISBN
- 9780333611807
- Titel
- Sociolinguistics - a reader
- Förlag
- Palgrave Macmillan
- Utgivningsår
- 1997
- Omfång
- 520 sidor
- Bandtyp
- Mått
- 156 x 235 mm
- Vikt
- 788 g
- Språk
- Svenska
Palgrave Macmillan 9780333611807 -

A history of modern Yemen
Häftad bok. Cambridge University Press. 2000. 271 (13) sidor.
Gott skick. En del understrykningar
Inrikes enhetsfrakt Sverige: 62 SEK- ISBN
- 9780521794824
- Titel
- A history of modern Yemen
- Författare
- Dresch, Paul
- Förlag
- New York : Cambridge University Press
- Utgivningsår
- 2000
- Språk
- English
Cambridge University Press 9780521794824 -

Saltets pris : svenska slavar i Nordafrika oc...
Inbunden bok. Nordic Academic Press. 1 uppl. 2014. 395 sidor.
Nyskick. Skyddsomslag i gott skick. Lite riss i överkanten på omslaget, stämplad recensionsex på övre snitt
Inrikes enhetsfrakt Sverige: 62 SEK- ISBN
- 9789187675164
- Titel
- Saltets pris : svenska slavar i Nordafrika och handeln i Medelhavet 1650-1770
- Författare
- Östlund, Joachim
- Förlag
- Nordic Academic Press
- Utgivningsår
- 2014
- Omfång
- 395 sidor
- Bandtyp
- Inbunden
- Mått
- 157 x 228 mm Ryggbredd 30 mm
- Vikt
- 770 g
- Språk
- Svenska
- Baksidestext
- När Jonas Thorsons föräldrar en dag år 1707 får veta att deras son har sålts som slav på en auktion i Alger på den ökända Barbariska kusten i Medelhavet är det ett skakande besked. Men Thorson är inte ensam: under perioden 1650 1770 tillfångatogs ett tusental svenska sjömän som var sysselsatta i den viktiga importen av salt till Sverige. I Saltets pris berättar Joachim Östlund historien om dessa sjömän. Genom en omfattande analys av diplomatisk korrespondens, tidningsartiklar, sjömansvisor, kollektutlysningar, äventyrsberättelser och akademiska skrifter visar han hur sjömännens öden påverkade samhälle och kultur i Sverige. Östlund studerar också konsulerna i Nordafrika, en yrkesgrupp som hade en avgörande roll för Sveriges kontakter med omvärlden. Konsulerna kunde friköpa svenska fångar och gjorde det samtidigt möjligt för svenska skeppare att ta del av det Osmanska rikets handel med afrikanska slavar. De svenska skeppens inblandning i denna slavhandel är tidigare helt outforskad. I centrum för boken står den lilla människans strävan att överleva i en tid präglad av kampen mellan imperier och globaliseringens konsekvenser.
Nordic Academic Press 1 9789187675164 -

Sprachwissenschaft - Grammatik - Interaktion...
Häftad bok. J.B. Metzler. 2013. 457 (7) sidor.
Mycket gott skick.
Inrikes enhetsfrakt Sverige: 62 SEK- ISBN
- 9783476023650
- Titel
- Sprachwissenschaft - Grammatik - Interaktion - Kognition
- Utgivningsår
- 2013
J.B. Metzler 9783476023650 -

The English language and linguistics companio...
Häftad bok. Houndsmill, Basingstoke, Hampshire ; New York : Palgrave Macmillan. 2010. 366 sidor.
Nära nyskick. Inga anteckningar eller dylikt
Inrikes enhetsfrakt Sverige: 62 SEK- ISBN
- 9781403989710
- Titel
- The English language and linguistics companion
- Författare
- Allan, Keith
- Förlag
- Houndsmill, Basingstoke, Hampshire ; New York : Palgrave Macmillan
- Språk
- English
- Baksidestext
- Includes bibliographical references and index.
Houndsmill, Basingstoke, Hampshire ; New York : Palgrave Macmillan 9781403989710 -

Tysk syntax för universitetsnivå
Häftad bok. Studentlitteratur AB. 1:4 uppl. 2012. 494 sidor.
Nära nyskick. Oläst
Inrikes enhetsfrakt Sverige: 62 SEK- ISBN
- 9789144041100
- Titel
- Tysk syntax för universitetsnivå
- Författare
- Persson, Ingemar
- Förlag
- Studentlitteratur AB
- Utgivningsår
- 2002
- Omfång
- 494 sidor
- Bandtyp
- Kartonnage
- Mått
- 155 x 223 mm Ryggbredd 34 mm
- Vikt
- 800 g
- Språk
- Svenska
- Baksidestext
- Tysk syntax är en klassiker i ny dräkt. En omfattande bearbetning av Tysk syntax för högskolebruk plus har resulterat i en modern lärobok för grammatikundervisningen vid universitet och högskolor.Boken är kontrastiv och betonar skillnaderna mellan svenska och tyska. Exemplifieringen är riklig. Med en klar disposition ger boken en systematisk beskrivning av det tyska standardspråkets syntax.Beskrivningen utgår från satsen och tar upp tre huvud-aspekter: satsdelarnas inre struktur, deras funktion och ordningen mellan dem. Tysk syntax är i första hand avsedd för studerande inom olika grundutbildningar, men kan med fördel användas som referensverk av den som vill fördjupa sig i det tyska språkets uppbyggnad.
Studentlitteratur AB 1:4 9789144041100 -

The Cambridge world history - Volume 5
Häftad bok. Cambridge . 2017. 684 (39) sidor.
Nära nyskick. Oläst/unread
Inrikes enhetsfrakt Sverige: 62 SEK- ISBN
- 9781108407724
- Titel
- The Cambridge world history
- Utgivningsår
- 2015
- Bandtyp
- Rel
- Språk
- English
Cambridge 9781108407724
Your country and preferred language.
Select your country Select languageDenna webbplats använder cookies för att säkerställa att du får den bästa upplevelsen.
Stäng
Välkommen till Sveriges största bokhandel
Här finns så gott som allt som givits ut på den svenska bokmarknaden under de senaste hundra åren.
- Handla mot faktura och öppet köp i 21 dagar
- Oavsett vikt och antal artiklar handlar du till enhetsfrakt från samma säljare i samma kundvagn





![History [elektronisk resurs] : a very short introduction](https://dez1v4fbcawql.cloudfront.net/metadata_thumb/978/019/285/9780192853523.jpg)









